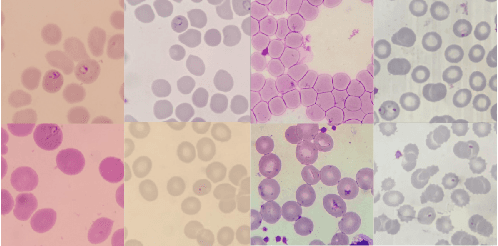
Figure 2 for Assessing Generalization Capabilities of Malaria Diagnostic Models from Thin Blood Smears

Abstract:Malaria remains a major global health challenge, particularly in low-resource settings where access to expert microscopy may be limited. Deep learning-based computer-aided diagnosis (CAD) systems have been developed and demonstrate promising performance on thin blood smear images. However, their clinical deployment may be hindered by limited generalization across sites with varying conditions. Yet very few practical solutions have been proposed. In this work, we investigate continual learning (CL) as a strategy to enhance the robustness of malaria CAD models to domain shifts. We frame the problem as a domain-incremental learning scenario, where a YOLO-based object detector must adapt to new acquisition sites while retaining performance on previously seen domains. We evaluate four CL strategies, two rehearsal-based and two regularization-based methods, on real-life conditions thanks to a multi-site clinical dataset of thin blood smear images. Our results suggest that CL, and rehearsal-based methods in particular, can significantly improve performance. These findings highlight the potential of continual learning to support the development of deployable, field-ready CAD tools for malaria.

Abstract:Malaria remains a significant global health challenge, necessitating rapid and accurate diagnostic methods. While computer-aided diagnosis (CAD) tools utilizing deep learning have shown promise, their generalization to diverse clinical settings remains poorly assessed. This study evaluates the generalization capabilities of a CAD model for malaria diagnosis from thin blood smear images across four sites. We explore strategies to enhance generalization, including fine-tuning and incremental learning. Our results demonstrate that incorporating site-specific data significantly improves model performance, paving the way for broader clinical application.